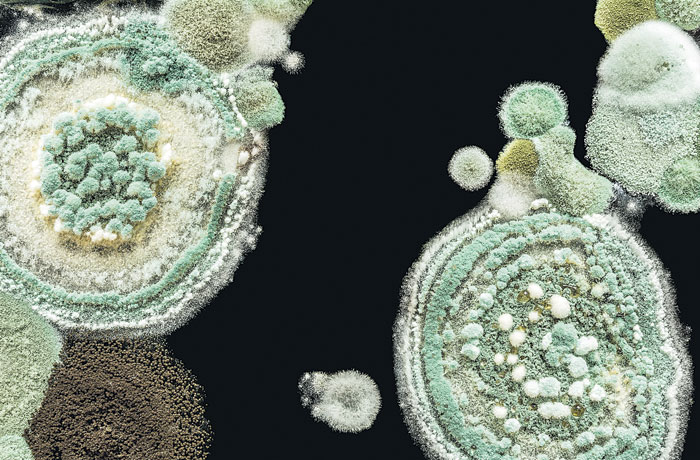

Ковид тренирует бактерии: антибиотики скоро могут стать бесполезными
Вина тому - слишком активное использование. Каждый год в середине ноября ВОЗ проводит Всемирную неделю правильного использования противомикробных препаратов. Рассказываем, почему нельзя лечиться антибиотиками от каждого чиха и пить сильнодействующие препараты «для профилактики».
13 октября в московском НИИ Склифосовского заработал масс-спектрометр. Аппарат стоит около 12 млн руб. Но быстро окупается. Его задача - за несколько часов выяснить, устойчива ли зараза к антибиотикам. Раньше такой анализ занимал несколько дней и мог стоить человеку жизни.
Суперзлодей
Человечество познакомилось с супербактерией зимой 2016 года. 70-летняя американка сломала ногу в Нью-Дели (Индия). Простая операция осложнилась воспалением, которое гасили антибиотиками. Ни один не сработал, пациентка умерла. ВОЗ называет антибиотикорезистентность одной из главных проблем медицины. Эра ковида ее обострила: люди закидываются таблетками для мнимой профилактики.
20 октября российские химиотерапевты и микробиологи попросили «отказаться от необоснованного назначения антибиотиков». Слепая вера в них популярна среди врачей общей практики. Но сталкиваются с последствиями специалисты, которые могут оказаться последними в жизни человека.
ВАЖНО!
- При ковиде антибиотики нужны, если развилась бактериальная инфекция. Пить популярный амоксициллин для профилактики бесполезно и опасно.
Убить, чтобы жить
«Анти» (против) + «биос» (жизнь) - уничтожают живые микроорганизмы. Вирусы (ОРВИ, ВИЧ, герпес) имеют иную природу. Антибиотики их не тронут. Но даже в поликлиниках делают эту ошибку. Возможно потому, что мы к ним привыкли. Антибиотиками кормят скот, обрабатывают поля, добавляют их в мыло. Миллиарды доз попали в окружающую среду и встретились с нониллионами бактерий. Те, что выжили, дали устойчивое потомство.
Опасно ли молоко
Роскачество борется за пересмотр технических регламентов в оценке молока: сегодня производители обязаны отчитываться только по четырем антибиотикам. А используются в животноводстве около 70!

Строго запрещается
1. Бросать курс, как только почувствовали себя лучше. Иначе вы - рассадник бактерий-ветеранов, которые выжили после первого удара.
2. Смешивать:
- с контрацептивами (особенно гормональный пластырь) - готовьтесь к беременности;
- с грейпфрутовым соком - может усилить действие и отравить;
- с алкоголем - минимум голова будет болеть (метронидазол, тинидазол), максимум - смерть (класс цефалоспорины, если лечение внутривенное).
3. Выкидывать таблетки в мусор. Сдавайте старые лекарства в аптеку на переработку.
Детское здоровье
В 2012 году группа немецких исследователей основала проект «Антибиотики. Проверка фактов». Главная рекомендация для родителей: «Чем меньше - тем лучше!» Ни цвет соплей, ни ушная боль не повод хвататься за антибиотик. В первую очередь установите причину болезни. До того убирайте симптомы, используя жаропонижающие и болеутоляющие.

Свернуть «тренировки»
Найти новый антибиотик сложно. Исследователи из Тюмени выделили эмерицеллипсин в 2018 году, но только в сентябре 2020-го заявили об эффективности. ВОЗ просит помогать ученым простыми действиями - не тренировать бактерий.
- Принимать антибиотики по инструкции.
- Делать прививки (чтобы не понадобилось дополнительное лечение).
- Тщательно мыть руки и еду.
- Следить за качеством воды (если живете не в городе, не пейте сырую воду).
- Использовать презервативы при новых контактах.
Кстати
- В 2018 году британец подхватил супергонорею. На отдыхе в Таиланде снял проститутку, а про кондом забыл. Как только выяснилось, что его ЗППП не лечится по старинке, горе-любовника изолировали от общества. Ему пришлось рассказать обо всех, кому передал подарочек. Так благодаря ученым о похождениях англичанина узнала его девушка.
Нобелевка из козявок и мочи
В начале 1870-х Вячеслав Манассеин и Алексей Полотебнов первыми открыли, что зеленая плесень пеницилл борется с кожными заболеваниями. В 1922 году британец Александр Флеминг посеял в чашку Петри свои сопли. Оказалось, что находящийся в них фермент лизоцим убил бактерии. В 1928-м он выделил из грибов пенициллин. Весной 1941 года первым пациентом стал Альберт Александер, констебль из Оксфорда.

Лекарства было мало, пришлось фильтровать мочу полицейского, чтобы использовать пенициллин повторно. Пациент поправлялся, однако препарата было мало, и он умер. В 1943 году выпустили 21 млрд доз для фронта. За открытие Флеминг получил Нобелевскую премию и рыцарский титул. Одновременно с Флемингом в СССР пенициллин открыла Зинаида Ермольева. В осажденном Сталинграде она наладила выпуск 50 тыс. доз ежедневно, чем спасла сотни тысяч жизней. Была удостоена звания профессора, Сталинской премии и ордена Ленина дважды.
*Организация запрещена на территории РФ

